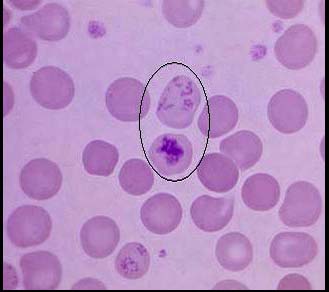

A.巨幼细胞贫血
B.遗传性球形红细胞增多症
C.缺铁性贫血
D.再障
E.PNH
[多选题]如图,圈中所示红细胞绝对值减少见于下列哪些疾病()A.巨幼细胞贫血B.遗传性球形红细胞增多症C.缺铁性贫血D.再障E.PNH
[多选题]如图,圈中所示红细胞绝对值减少见于下列哪些疾病()A.巨幼细胞贫血B.遗传性球形红细胞增多症C.缺铁性贫血D.再障E.PNH
[多选题]如图,圈中所示红细胞绝对值减少见于下列哪些疾病()A.巨幼细胞贫血B.遗传性球形红细胞增多症C.缺铁性贫血D.再障E.PNH
[多选题]如图,圈中所示红细胞绝对值减少见于下列哪些疾病()A.巨幼细胞贫血B.遗传性球形红细胞增多症C.缺铁性贫血D.再障E.PNH
[多选题]如图,圈中所示红细胞绝对值减少见于下列哪些疾病()A.巨幼细胞贫血B.遗传性球形红细胞增多症C.缺铁性贫血D.再障E.PNH
[单选题]如图,若外周血圈中所示红细胞增多,最常见于()A.白血病B.缺铁性贫血C.溶血性贫血D.骨髓病性贫血E.再生障碍性贫血
[单选题]如图,若外周血圈中所示红细胞增多,最常见于()A.白血病B.缺铁性贫血C.溶血性贫血D.骨髓病性贫血E.再生障碍性贫血
[单选题]图所示是()A.中性粒细胞B.红细胞C.正常血小板D.嗜酸性粒细胞E.巨型血小板
[多选题]下面哪些符合脑膜瘤(如图所示)表现()A.脑膜瘤起病慢、病程长,可达数年之久B.初期症状及体征不明显,以后逐渐出现颅内高压征及局部定位症状及体征C.颅
[多选题]眼睑肌包括(如图)()A.提上睑肌B.眼轮匝肌C.上眼睑肌D.上睑板腺E.以上全对